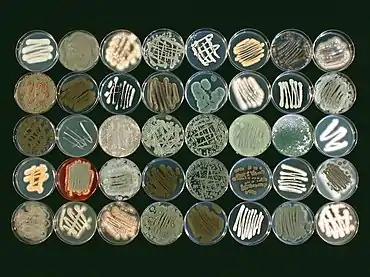

| Part of a series of overviews on |
| Marine life |
|---|
![]() |
Marine fungi are species of fungi that live in marine or estuarine environments. They are not a taxonomic group, but share a common habitat. Obligate marine fungi grow exclusively in the marine habitat while wholly or sporadically submerged in sea water. Facultative marine fungi normally occupy terrestrial or freshwater habitats, but are capable of living or even sporulating in a marine habitat. About 444 species of marine fungi have been described, including seven genera and ten species of basidiomycetes, and 177 genera and 360 species of ascomycetes. The remainder of the marine fungi are chytrids and mitosporic or asexual fungi.[2] Many species of marine fungi are known only from spores and it is likely a large number of species have yet to be discovered.[3] In fact, it is thought that less than 1% of all marine fungal species have been described, due to difficulty in targeting marine fungal DNA and difficulties that arise in attempting to grow cultures of marine fungi.[4] It is impracticable to culture many of these fungi, but their nature can be investigated by examining seawater samples and undertaking rDNA analysis of the fungal material found.[3]
Different marine habitats support very different fungal communities. Fungi can be found in niches ranging from ocean depths and coastal waters to mangrove swamps and estuaries with low salinity levels.[5] Marine fungi can be saprobic or parasitic on animals, saprobic or parasitic on algae, saprobic on plants or saprobic on dead wood.[2]
Overview
Terrestrial fungi play critical roles in nutrient cycling and food webs and can shape macroorganism communities as parasites and mutualists. Although estimates for the number of fungal species on the planet range from 1.5 to over 5 million, likely fewer than 10% of fungi have been identified so far. To date, a relatively small percentage of described species are associated with marine environments, with ~1,100 species retrieved exclusively from the marine environment. Nevertheless, fungi have been found in nearly every marine habitat explored, from the surface of the ocean to kilometers below ocean sediments. Fungi are hypothesized to contribute to phytoplankton population cycles and the biological carbon pump and are active in the chemistry of marine sediments. Many fungi have been identified as commensals or pathogens of marine animals (e.g., corals and sponges), plants, and algae. Despite their varied roles, remarkably little is known about the diversity of this major branch of eukaryotic life in marine ecosystems or their ecological functions.[6]
Fungi represent a large and diverse group of microorganisms in microbiological communities in the marine environment and have an important role in nutrient cycling.[7] They are divided into two major groups; obligate marine fungi and facultative marine fungi.[8] Obligate marine fungi are adapted to reproduce in the aquatic environment, while facultative marine fungi can grow in aquatic as well as terrestrial environments.[8] Marine fungi are called marine-derived fungi when their facultative or obligate state is not certain.[9]
Marine fungal species occur as saprobes, parasites, or symbionts and colonize a wide range of substrates, such as sponges, corals, mangroves, seagrasses and algae.[10][11][9]
Factors that influence whether or not marine fungi are present in any particular location include the water temperature, its salinity, the water movement, the presence of suitable substrates for colonization, the presence of propagules in the water, interspecific competition, pollution and the oxygen content of the water.[5]
Some marine fungi which have ventured into the sea from terrestrial habitats include species that burrow into sand grains, living in the pores. Others live inside stony corals, and may become pathogenic if the coral is stressed by rising sea temperatures.[3][12]
In 2011 the phylogeny of marine fungi was elucidated by analysis of their small subunit ribosomal DNA sequences. Thirty six new marine lineages were found, the majority of which were chytrids but also some filamentous and multicellular fungi. The majority of the species found were ascomycetous and basidiomycetous yeasts.[13]
The secondary metabolites produced by marine fungi have high potential for use in biotechnological, medical and industrial applications.[14]
Evolution
In contrast to plants and animals, the early fossil record of the fungi is meager. Since fungi do not biomineralise, they do not readily enter the fossil record. Fungal fossils are difficult to distinguish from those of other microbes, and are most easily identified when they resemble extant fungi.[15]
The earliest fossils possessing features typical of fungi date to the Paleoproterozoic era, some 2,400 million years ago (Ma). These multicellular benthic organisms had filamentous structures capable of anastomosis, in which hyphal branches recombine.[16] Other recent studies (2009) estimate the arrival of fungal organisms at about 760–1060 Ma on the basis of comparisons of the rate of evolution in closely related groups.[17]

For much of the Paleozoic Era (542–251 Ma), the fungi appear to have been aquatic and consisted of organisms similar to the extant Chytrids in having flagellum-bearing spores.[18] Phylogenetic analyses suggest that the flagellum was lost early in the evolutionary history of the fungi, and consequently, the majority of fungal species lack a flagellum.[19] Evidence from DNA analysis suggests that all fungi are descended from one common ancestor, at least 600 million years ago. It is probable that these earliest fungi lived in water, and had flagella. Fungi moved to land at about the same time as plants, about 460 million years ago, at least.[20] Although fungi are opisthokonts—a grouping of evolutionarily related organisms broadly characterized by a single posterior flagellum—all phyla except for the chytrids have lost their posterior flagella.[21]
The evolutionary adaptation from an aquatic to a terrestrial lifestyle necessitated a diversification of ecological strategies for obtaining nutrients, including parasitism, saprobism, and the development of mutualistic relationships such as mycorrhiza and lichenization.[22] Recent (2009) studies suggest that the ancestral ecological state of the Ascomycota was saprobism, and that independent lichenization events have occurred multiple times.[23]
The growth of fungi as hyphae on or in solid substrates or as single cells in aquatic environments is adapted for the efficient extraction of nutrients, because these growth forms have high surface area to volume ratios.[24] Hyphae are specifically adapted for growth on solid surfaces, and to invade substrates and tissues.[25] They can exert large penetrative mechanical forces; for example, many plant pathogens, including Magnaporthe grisea, form a structure called an appressorium that evolved to puncture plant tissues.[26] The pressure generated by the appressorium, directed against the plant epidermis, can exceed 8 megapascals (1,200 psi).[26] The filamentous fungus Paecilomyces lilacinus uses a similar structure to penetrate the eggs of nematodes.[27]
Fungi were considered to be part of the plant kingdom until the mid-20th century. By the middle of the 20th century Fungi were considered a distinct kingdom, and the newly recognized kingdom Fungi becoming the third major kingdom of multicellular eukaryotes with kingdom Plantae and kingdom Animalia, the distinguishing feature between these kingdoms being the way they obtain nutrition.[28]
Marine plants
Mangroves
.jpg.webp)

The greatest number of known species of marine fungi are from mangrove swamps.[2] In one study, blocks of mangrove wood and pieces of driftwood of Avicennia alba, Bruguiera cylindrica and Rhizophora apiculata were examined to identify the lignicolous (wood-decaying) fungi they hosted. Also tested were Nypa fruticans, a mangrove palm and Acanthus ilicifolius, a plant often associated with mangroves. Each material was found to have its own characteristic fungi, the greatest diversity being among those growing on the mangrove palm. It was surmised that this was because the salinity was lower in the estuaries and creeks where Nypa grew, and so it required a lesser degree of adaptation for the fungi to flourish there. Some of these species were closely related to fungi on terrestrial palms. Other studies have shown that driftwood hosts more species of fungus than do exposed test blocks of wood of a similar kind. The mangrove leaf litter also supported a large fungal community which was different from that on the wood and living material. However, few of these were multicellular, higher marine fungi.[5]
Other plants


The sea snail Littoraria irrorata damages plants of Spartina in the coastal sea marshes where it lives, which enables spores of intertidal ascomycetous fungi to colonise the plant. The snail eats the fungal growth in preference to the grass itself. This mutualism between the snail and the fungus is considered to be the first example of husbandry among invertebrate animals outside the class Insecta.[30]
Eelgrass, Zostera marina, is sometimes affected by seagrass wasting disease. The primary cause of this seems to be pathogenic strains of the protist Labyrinthula zosterae, but it is thought that fungal pathogens also contribute and may predispose the eelgrass to disease.[31][32]
Wood

Many marine fungi are very specific as to which species of floating and submerged wood they colonise. A range of species of fungi colonise beech, while oak supports a different community. When a fungal propagule lands on a suitable piece of wood, it will grow if no other fungi are present. If the wood is already colonised by another fungal species, growth will depend on whether that fungus produces antifungal chemicals and whether the new arrival can resist them. The chemical properties of colonizing fungi also affect the animal communities that graze on them: in one study, when hyphae from five different species of marine fungi were fed to nematodes, one species supported less than half the number of nematodes per mg of hyphae than did the others.[33]
Detection of fungi in wood may involve incubation at a suitable temperature in a suitable water medium for a period of six months to upward of eighteen months.[33]
Lichens

Lichens are mutualistic associations between fungi, usually an ascomycete with a basidiomycete,[34] and an alga or a cyanobacterium. Several lichens, including Arthopyrenia halodytes, Pharcidia laminariicola, Pharcidia rhachiana and Turgidosculum ulvae, are found in marine environments.[2] Many more occur in the splash zone, where they occupy different vertical zones depending on how tolerant they are to submersion.[35] Lichen-like fossils have been found in the Doushantuo Formation in China dating back about 600 million years ago.[36]
Fungi from Verrucariales also form marine lichens with the brown algae Petroderma maculiforme,[37] and have a symbiotic relationship with seaweed like (rockweed) and Blidingia minima, where the algae are the dominant components. The fungi is thought to help the rockweeds to resist desiccation when exposed to air.[38][39] In addition, lichens can also use yellow-green algae (Heterococcus) as their symbiotic partner.[40]
Lichen-like fossils consisting of coccoid cells (cyanobacteria?) and thin filaments (mucoromycotinan Glomeromycota?) are permineralized in marine phosphorite of the Doushantuo Formation in southern China. These fossils are thought to be 551 to 635 million years old or Ediacaran.[41] Ediacaran acritarchs also have many similarities with Glomeromycotan vesicles and spores.[42] It has also been claimed that Ediacaran fossils including Dickinsonia,[43] were lichens,[44] although this claim is controversial.[45] Endosymbiotic Glomeromycota comparable with living Geosiphon may extend back into the Proterozoic in the form of 1500 million year old Horodyskia[46] and 2200 million year old Diskagma.[47] Discovery of these fossils suggest that marine fungi developed symbiotic partnerships with photoautotrophs long before the evolution of vascular plants.
Algae and phytoplankton

Marine fungi associated with algae are largely unexplored, despite their ecological role and potential industrial applications. For example, it has been shown that fungi associated with algae produce many bioactive secondary metabolites.[49][50][51] Algae derived fungi can be associated with a variety of algae, including brown (e.g., Agarum clathratum, Fucus sp., Laminaria sp., Sargassum sp.), green (e.g., Ulva sp., Enteromorpha sp., Flabellia sp.), or red (e.g. Chondrus sp., Dilsea sp., Ceramium sp.) algae.[52][53][54][55][56][9]
Almost one-third of all known marine fungal species are associated with algae.[57] The most commonly described fungi associated with algae belong to the Ascomycota and are represented by a wide diversity of genera such as Acremonium, Alternaria, Aspergillus, Cladosporium, Phoma, Penicillium, Trichoderma, Emericellopsis, Retrosium, Spathulospora, Pontogenia and Sigmoidea.[53][58][55][56][59][60][61][9]
Rhyzophydium littoreum is a marine chytrid, a primitive fungus that infects green algae in estuaries. It obtains nutrients from the host alga and produces swimming zoospores that must survive in open water, a low nutrient environment, until a new host is encountered.[33] Another fungus, Ascochyta salicorniae, found growing on seaweed is being investigated for its action against malaria,[62] a mosquito-borne infectious disease of humans and other animals.
Invertebrates
The American lobster (Homarus americanus), like many other marine crustaceans, incubates its eggs beneath its tail segments. Here they are exposed to water-borne micro-organisms including fungi during their long period of development. The lobster has a symbiotic relationship with a gram-negative bacterium that has anti-fungal properties. This bacterium grows over the eggs and protects them from infection by the pathogenic fungus-like oomycete Lagenidium callinectes. The metabolite produced by the bacterium is tyrosol, a 4-hydroxyphenethyl alcohol, an antibiotic substance also produced by some terrestrial fungi. Similarly, a shrimp found in estuaries, Palaemon macrodactylis, has a symbiotic bacterium that produces 2,3-indolenedione, a substance that is also toxic to the oomycete Lagenidium callinectes.[63]
Vertebrates

Whales, porpoises and dolphins are susceptible to fungal diseases but these have been little researched in the field. Mortalities from fungal disease have been reported in captive killer whales; it is thought that stress due to captive conditions may have been predisposing. Transmission among animals in the open sea may naturally limit the spread of fungal diseases. Infectious fungi known from killer whales include Aspergillus fumigatus, Candida albicans and Saksenaea vasiformis. Fungal infections in other cetaceans include Coccidioides immitis, Cryptococcus neoformans, Loboa loboi, Rhizopus sp., Aspergillus flavus, Blastomyces dermatitidis, Cladophialophora bantiana, Histoplasma capsulatum, Mucor sp., Sporothrix schenckii and Trichophyton sp.[64]
Salmonids farmed in cages in marine environments may be affected by a number of different fungal infections. Exophiala salmonis causes an infection in which growth of hyphae in the kidneys causes swelling of the abdomen. A cellular response by the fish aims to isolate the fungus by walling it off. Fish are also susceptible to fungus-like oomycetes including Branchiomyces which affects the gills of various fishes, and Saprolegnia which attacks damaged tissue.[65]
Marine sediment
Ascomycota, Basidiomycota, and Chytridiomycota have been observed in marine sediments ranging in depth from 0 to 1740 meters beneath the ocean floor. One study analyzed subsurface samples of marine sediment between these depths and isolated all observable fungi. Isolates showed that most subsurface fungal diversity was found between depths of 0 to 25 meters below the sea floor with Fusarium oxysporum and Rhodotorula mucilaginosa being the most prominent. Overall, the ascomycota are the dominant subsurface phylum.[66] Almost all fungal species recovered have also been observed in terrestrial sediments with spore-sourcing indicating terrestrial origin.[66][67]
Contrary to previous beliefs, deep subsurface marine fungi actively grow and germinate, with some studies showing increased growth rates under high hydrostatic pressures. Though the methods by which marine fungi are able to survive the extreme conditions of the seafloor and below is largely unknown, Saccharomyces cerevisiae shines some light onto adaptations that make it possible. This fungus strengthens its outer membrane in order to endure higher hydrostatic pressures.[66]
Several sediment-dwelling marine fungi are involved in biogeochemical processes. Fusarium oxysporum and Fusarium solani are denitrifiers both in marine and terrestrial environments.[66][68] Some are co-denitrifying, fixing nitrogen into nitrous oxide and dinitrogen.[67] Still others process organic matter including carbohydrate, proteins, and lipids. Ocean crust fungi, like those found around hydrothermal vents, decompose organic matter, and play various roles in manganese and arsenic cycling.[6]
Sediment-bound marine fungi played a major role in breaking down oil spilled from the Deepwater Horizons disaster in 2010. Aspergillus, Penicillium, and Fusarium species, among others, can degrade high-molecular-weight hydrocarbons as well as assist hydrocarbon-degrading bacteria.[6]
Arctic marine fungi

Marine fungi have been observed as far north as the Arctic Ocean. Chytridiomycota, the dominant parasitic fungal organism in Arctic waters, take advantage of phytoplankton blooms in brine channels caused by warming temperatures and increased light penetration through the ice. These fungi parasitize diatoms, thereby controlling algal blooms and recycling carbon back into the microbial food web. Arctic blooms also provide conducive environments for other parasitic fungi. Light levels and seasonal factors, such as temperature and salinity, also control chytrid activity independently of phytoplankton populations. During periods of low temperatures and phytoplankton levels, Aureobasidium and Cladosporium populations overtake those of chytrids within the brine channels.[70]
Food webs and the mycoloop




Human uses
Biomass processors
Medical
Marine fungi produce antiviral and antibacterial compounds as metabolites with upwards of 1,000 having realized and potential uses as anticancer, anti-diabetic, and anti-inflammatory drugs.[75][76]
The antiviral properties of marine fungi were realized in 1988 after their compounds were used to successfully treat the H1N1 flu virus. In addition to H1N1, antiviral compounds isolated from marine fungi have been shown to have virucidal effects on HIV, herpes simplex 1 and 2, Porcine Reproductive and Respiratory Syndrome Virus, and Respiratory Syncytial Virus. Most of these antiviral metabolites were isolated from species of Aspergillus, Penicillium, Cladosporium, Stachybotrys, and Neosartorya. These metabolites inhibit the virus's ability to replicate, thereby slowing infections.[75]
Mangrove-associated fungi have prominent antibacterial effects on several common pathogenic human bacteria including, Staphylococcus aureus and Pseudomonas aeruginosa. High competition between organisms within mangrove niches lead to increases in antibacterial substances produced by these fungi as defensive agents.[77] Penicillium and Aspergillus species are the largest producers of antibacterial compounds among the marine fungi.[78]
Various deep-sea marine fungi species have recently been shown to produce anti-cancer metabolites. One study uncovered 199 novel cytotoxic compounds with anticancer potential. In addition to cytotoxic metabolites, these compounds have structures capable of disrupting cancer-activated telomerases via DNA binding. Others inhibit the topoisomerase enzyme from continuing to aid in the repair and replication of cancer cells.[76]
See also
References
- ↑ Paz, Z.; Komon-Zelazowska, M.; Druzhinina, I. S.; Aveskamp, M. M.; Shnaiderman, A.; Aluma, Y.; Carmeli, S.; Ilan, M.; Yarden, O. (30 January 2010). "Diversity and potential antifungal properties of fungi associated with a Mediterranean sponge". Fungal Diversity. 42 (1): 17–26. doi:10.1007/s13225-010-0020-x. S2CID 45289302.
- 1 2 3 4 Species of Higher Marine Fungi Archived 2013-04-22 at the Wayback Machine University of Mississippi. Retrieved 2012-02-05.
- 1 2 3 "Cool New Paper: Marine Fungi". Teaching Biology. Archived from the original on March 16, 2012.
- ↑ Gladfelter, Amy S.; James, Timothy Y.; Amend, Anthony S. (March 2019). "Marine fungi". Current Biology. 29 (6): R191–R195. doi:10.1016/j.cub.2019.02.009. PMID 30889385.
- 1 2 3 E. B. Gareth Jones (2000). "Marine fungi: some factors influencing biodiversity" (PDF). Fungal Diversity. 4: 53–73.
- 1 2 3 4 Amend, A., Burgaud, G., Cunliffe, M., Edgcomb, V.P., Ettinger, C.L., Gutiérrez, M.H., Heitman, J., Hom, E.F., Ianiri, G., Jones, A.C. and Kagami, M. (2019) "Fungi in the marine environment: Open questions and unsolved problems". MBio, 10(2): e01189-18. doi:10.1128/mBio.01189-18.
Modified text was copied from this source, which is available under a Creative Commons Attribution 4.0 International License. - ↑ Tisthammer, K.H.; Cobian, G.M.; Amend, A.S. Global biogeography of marine fungi is shaped by the environment. Fungal Ecol. 2016, 19, 39–46.
- 1 2 Raghukumar, S. The marine environment and the role of fungi. In Fungi in Coastal and Oceanic Marine Ecosystems: Marine Fungi; Springer International Publishing: Cham, Switzerland, 2017; pp. 17–38.
- 1 2 3 4 Patyshakuliyeva, A., Falkoski, D.L., Wiebenga, A., Timmermans, K. and De Vries, R.P. (2020) "Macroalgae derived fungi have high abilities to degrade algal polymers". Microorganisms, 8(1): 52. doi:10.3390/microorganisms8010052.
Modified text was copied from this source, which is available under a Creative Commons Attribution 4.0 International License. - ↑ Jones, E.B.G.; Suetrong, S.; Sakayaroj, J.; Bahkali, A.H.; Abdel-Wahab, M.A.; Boekhout, T.; Pang, K.-L. Classification of marine Ascomycota, Basidiomycota, Blastocladiomycota and Chytridiomycota. Fungal Divers. 2015, 73, 1–72.
- ↑ Debbab, A.; Aly, A.H.; Proksch, P. Mangrove derived fungal endophytes–a chemical and biological perception. Fungal Divers. 2013, 61, 1–27.
- ↑ Holmquist, G. U.; H. W. Walker & Stahr H. M. (1983). "Influence of Temperature, pH, Water Activity and Antifungal Agents on Growth of Aspergillus flavus and A. parasiticus". Journal of Food Science. 48 (3): 778–782. doi:10.1111/j.1365-2621.1983.tb14897.x.
- ↑ Richards, Thomas A.; Jones, Meredith D.M.; Leonard, Guy; Bass, David (15 January 2012). "Marine Fungi: Their Ecology and Molecular Diversity". Annual Review of Marine Science. 4 (1): 495–522. Bibcode:2012ARMS....4..495R. doi:10.1146/annurev-marine-120710-100802. PMID 22457985.
- ↑ Marine Fungi Retrieved 2012-02-06.
- ↑ Donoghue MJ; Cracraft J (2004). Assembling the Tree of Life. Oxford (Oxfordshire), UK: Oxford University Press. p. 187. ISBN 978-0-19-517234-8.
- ↑ Bengtson, Stefan; Rasmussen, Birger; Ivarsson, Magnus; Muhling, Janet; Broman, Curt; Marone, Federica; Stampanoni, Marco; Bekker, Andrey (24 April 2017). "Fungus-like mycelial fossils in 2.4-billion-year-old vesicular basalt". Nature Ecology & Evolution. 1 (6): 0141. doi:10.1038/s41559-017-0141. hdl:20.500.11937/67718. ISSN 2397-334X. PMID 28812648. S2CID 25586788.
- ↑ Lucking R, Huhndorf S, Pfister D, Plata ER, Lumbsch H (2009). "Fungi evolved right on track". Mycologia. 101 (6): 810–822. doi:10.3852/09-016. PMID 19927746. S2CID 6689439.
- ↑ James TY; et al. (2006). "Reconstructing the early evolution of Fungi using a six-gene phylogeny". Nature. 443 (7113): 818–22. Bibcode:2006Natur.443..818J. doi:10.1038/nature05110. PMID 17051209. S2CID 4302864.
- ↑ Liu YJ, Hodson MC, Hall BD (2006). "Loss of the flagellum happened only once in the fungal lineage: phylogenetic structure of Kingdom Fungi inferred from RNA polymerase II subunit genes". BMC Evolutionary Biology. 6 (1): 74. doi:10.1186/1471-2148-6-74. PMC 1599754. PMID 17010206.
- ↑ "CK12-Foundation". flexbooks.ck12.org. Retrieved 2020-05-19.
- ↑ Steenkamp ET, Wright J, Baldauf SL (January 2006). "The protistan origins of animals and fungi". Molecular Biology and Evolution. 23 (1): 93–106. doi:10.1093/molbev/msj011. PMID 16151185.
- ↑ Taylor and Taylor, pp. 84–94 and 106–107.
- ↑ Schoch CL; Sung G-H; López-Giráldez F; et al. (2009). "The Ascomycota tree of life: A phylum-wide phylogeny clarifies the origin and evolution of fundamental reproductive and ecological traits". Systematic Biology. 58 (2): 224–39. doi:10.1093/sysbio/syp020. PMID 20525580.
- ↑ Moss ST (1986). The Biology of Marine Fungi. Cambridge, UK: Cambridge University Press. p. 76. ISBN 978-0-521-30899-1.
- ↑ Peñalva MA, Arst HN (September 2002). "Regulation of gene expression by ambient pH in filamentous fungi and yeasts". Microbiology and Molecular Biology Reviews. 66 (3): 426–46, table of contents. doi:10.1128/MMBR.66.3.426-446.2002. PMC 120796. PMID 12208998.
- 1 2 Howard RJ, Ferrari MA, Roach DH, Money NP (December 1991). "Penetration of hard substrates by a fungus employing enormous turgor pressures". Proceedings of the National Academy of Sciences of the United States of America. 88 (24): 11281–4. Bibcode:1991PNAS...8811281H. doi:10.1073/pnas.88.24.11281. PMC 53118. PMID 1837147.
- ↑ Money NP (1998). "Mechanics of invasive fungal growth and the significance of turgor in plant infection". Molecular Genetics of Host-Specific Toxins in Plant Disease: Proceedings of the 3rd Tottori International Symposium on Host-Specific Toxins, Daisen, Tottori, Japan, August 24–29, 1997. Netherlands: Kluwer Academic Publishers. pp. 261–271. ISBN 978-0-7923-4981-5.
- ↑ "Fungus - Evolution and phylogeny of fungi". Encyclopedia Britannica. Retrieved 2020-05-19.
- ↑ Fryar, S.C., Haelewaters, D. and Catcheside, D.E. (2019) "Annabella australiensis gen. & sp. nov.(Helotiales, Cordieritidaceae) from South Australian mangroves". Mycological Progress, 18(7): 973–981. doi:10.1007/s11557-019-01499-x.
- ↑ Silliman B. R. & S. Y. Newell (2003). "Fungal farming in a snail". PNAS. 100 (26): 15643–15648. Bibcode:2003PNAS..10015643S. doi:10.1073/pnas.2535227100. PMC 307621. PMID 14657360.
- ↑ Disease Analysis in San Juan Archipelago Archived 2013-09-12 at the Wayback Machine Friday Harbor Laboratories Seagrass Lab. Retrieved 2012-02-06.
- ↑ Short, Frederick T.; Robert G. Coles (2001-11-06). Global seagrass research methods. Elsevier. p. 414. ISBN 9780080525617.
- 1 2 3 Moss, Stephen T. (1986). The biology of marine fungi. CUP Archive. pp. 65–70. ISBN 9780521308991.
- ↑ Spribille, Toby; Tuovinen, Veera; Resl, Philipp; Vanderpool, Dan; Wolinski, Heimo; Aime, M. Catherine; Schneider, Kevin; Stabentheiner, Edith; Toome-Heller, Merje; Thor, Göran; Mayrhofer, Helmut; Johannesson, Hanna; McCutcheon, John P. (29 July 2016). "Basidiomycete yeasts in the cortex of ascomycete macrolichens". Science. 353 (6298): 488–492. Bibcode:2016Sci...353..488S. doi:10.1126/science.aaf8287. PMC 5793994. PMID 27445309.
- ↑ Freshwater and marine lichen-forming fungi Retrieved 2012-02-06.
- ↑ Yuan X, Xiao S, Taylor TN.; Xiao; Taylor (2005). "Lichen-like symbiosis 600 million years ago". Science. 308 (5724): 1017–20. Bibcode:2005Sci...308.1017Y. doi:10.1126/science.1111347. PMID 15890881. S2CID 27083645.
{{cite journal}}: CS1 maint: multiple names: authors list (link) - ↑ Sanders, W. B.; Moe, R. L.; Ascaso, C. (2004). "The intertidal marine lichen formed by the pyrenomycete fungus Verrucaria tavaresiae (Ascomycotina) and the brown alga Petroderma maculiforme (Phaeophyceae): thallus organization and symbiont interaction – NCBI". American Journal of Botany. 91 (4): 511–22. doi:10.3732/ajb.91.4.511. hdl:10261/31799. PMID 21653406.
- ↑ "Mutualisms between fungi and algae – New Brunswick Museum". Archived from the original on 18 September 2018. Retrieved 4 October 2018.
- ↑ Miller, Kathy Ann; Pérez-Ortega, Sergio (May 2018). "Challenging the lichen concept: Turgidosculum ulvae – Cambridge". The Lichenologist. 50 (3): 341–356. doi:10.1017/S0024282918000117. S2CID 90117544. Archived from the original on 7 October 2018. Retrieved 7 October 2018.
- ↑ Rybalka, N.; Wolf, M.; Andersen, R. A.; Friedl, T. (2013). "Congruence of chloroplast – BMC Evolutionary Biology – BioMed Central". BMC Evolutionary Biology. 13: 39. doi:10.1186/1471-2148-13-39. PMC 3598724. PMID 23402662.
- ↑ Yuan X, Xiao S, Taylor TN (2005). "Lichen-like symbiosis 600 million years ago". Science. 308 (5724): 1017–1020. Bibcode:2005Sci...308.1017Y. doi:10.1126/science.1111347. PMID 15890881. S2CID 27083645.
- ↑ Retallack G.J. (2015). "Acritarch evidence of a late Precambrian adaptive radiation of Fungi" (PDF). Botanica Pacifica. 4 (2): 19–33. doi:10.17581/bp.2015.04203. Archived (PDF) from the original on 22 December 2016. Retrieved 22 December 2016.
- ↑ Retallack GJ. (2007). "Growth, decay and burial compaction of Dickinsonia, an iconic Ediacaran fossil". Alcheringa: An Australasian Journal of Palaeontology. 31 (3): 215–240. doi:10.1080/03115510701484705. S2CID 17181699.
- ↑ Retallack GJ. (1994). "Were the Ediacaran Fossils Lichens?". Paleobiology. 20 (4): 523–544. doi:10.1017/s0094837300012975. JSTOR 2401233. S2CID 129180481.
- ↑ Switek B (2012). "Controversial claim puts life on land 65 million years early". Nature. doi:10.1038/nature.2012.12017. S2CID 130305901. Archived from the original on 1 January 2013. Retrieved 2 January 2013.
- ↑ Retallack, G.J.; Dunn, K.L.; Saxby, J. (2015). "Problematic Mesoproterozoic fossil Horodyskia from Glacier National Park, Montana, USA". Precambrian Research. 226: 125–142. Bibcode:2013PreR..226..125R. doi:10.1016/j.precamres.2012.12.005.
- ↑ Retallack, G.J.; Krull, E.S.; Thackray, G.D.; Parkinson, D. (2013). "Problematic urn-shaped fossils from a Paleoproterozoic (2.2 Ga) paleosol in South Africa". Precambrian Research. 235: 71–87. Bibcode:2013PreR..235...71R. doi:10.1016/j.precamres.2013.05.015.
- ↑ Hassett, BT; Gradinger, R (2016). "Chytrids dominate arctic marine fungal communities". Environ Microbiol. 18 (6): 2001–2009. doi:10.1111/1462-2920.13216. PMID 26754171.
- ↑ Overy, D.P.; Bayman, P.; Kerr, R.G.; Bills, G.F. An assessment of natural product discovery from marine (sensu stricto) and marine-derived fungi. Mycology 2014, 5, 145–167.
- ↑ Flewelling, A.J.; Currie, J.; Gray, C.A.; Johnson, J.A. Endophytes from marine macroalgae: Promising sources of novel natural products. Curr. Sci. 2015, 109, 88–111.
- ↑ Miao, F.; Zuo, J.; Liu, X.; Ji, N. Algicidal activities of secondary metabolites of marine macroalgal-derived endophytic fungi. J. Oceanol. Limnol. 2019, 37, 112–121.
- ↑ Gnavi, G.; Garzoli, L.; Poli, A.; Prigione, V.; Burgaud, G.; Varese, G.C. The culturable mycobiota of Flabellia petiolata: First survey of marine fungi associated to a Mediterranean green alga. PLoS ONE 2017, 12, e0175941.
- 1 2 Kohlmeyer, J.; Volkmann-Kohlmeyer, B. Illustrated key to the filamentous higher marine fungi. Bot. Mar. 1991, 34, 1–61.
- ↑ Stanley, S.J. Observations on the seasonal occurrence of marine endophytic and parasitic fungi. Can. J. Bot. 1992, 70, 2089–2096.
- 1 2 Zuccaro, A.; Schoch, C.L.; Spatafora, J.W.; Kohlmeyer, J.; Draeger, S.; Mitchell, J.I. Detection and identification of fungi intimately associated with the brown seaweed Fucus serratus. Appl. Environ. Microbiol. 2008, 74, 931–941.
- 1 2 Lee, S.; Park, M.S.; Lee, H.; Kim, J.J.; Eimes, J.A.; Lim, Y.W. Fungal diversity and enzyme activity associated with the macroalgae, Agarum clathratum. Mycobiology 2019, 47, 50–58.
- ↑ Balabanova, L.; Slepchenko, L.; Son, O.; Tekutyeva, L. Biotechnology potential of marine fungi degrading plant and algae polymeric substrates. Front. Microbiol. 2018, 9, 15–27.
- ↑ Stanley, S.J. Observations on the seasonal occurrence of marine endophytic and parasitic fungi. Can. J. Bot. 1992, 70, 2089–2096. [Google Scholar] [CrossRef]
- ↑ Zuccaro, A.; Summerbell, R.C.; Gams, W.; Schroers, H.-J.; Mitchell, J.I. A new Acremonium species associated with Fucus spp., and its affinity with a phylogenetically distinct marine Emericellopsis clade. Stud. Mycol. 2004, 50, 283–297.
- ↑ Kohlmeyer, J.; Kohlmeyer, E. Marine Mycology: The Higher Fungi; Elsevier: Amsterdam, the Netherlands, 2013.
- ↑ Wainwright, B.J.; Bauman, A.G.; Zahn, G.L.; Todd, P.A.; Huang, D. Characterization of fungal biodiversity and communities associated with the reef macroalga Sargassum ilicifolium reveals fungal community differentiation according to geographic locality and algal structure. Mar. Biodivers. 2019, 49, 2601–2608.
- ↑ Osterhage C.; R. Kaminsky; G. König & A. D. Wright (2000). "Ascosalipyrrolidinone A, an Antimicrobial Alkaloid, from the Obligate Marine Fungus Ascochyta salicorniae". Journal of Organic Chemistry. 65 (20): 6412–6417. doi:10.1021/jo000307g. PMID 11052082.
- ↑ Gil-Turnes, M. Sofia & William Fenical (1992). "Embryos of Homarus americanus are Protected by Epibiotic Bacteria". The Biological Bulletin. 182 (1): 105–108. doi:10.2307/1542184. JSTOR 1542184. PMID 29304709.
- ↑ Gaydos, Joseph K.; Balcomb, Kenneth C.; Osborne, Richard W.; Dierauf, Leslie. A Review of Potential Infectious Disease Threats to Southern Resident Killer Whales (Orcinus orca) (PDF) (Report). Archived from the original (PDF) on 2016-03-04. Retrieved 2012-09-28.
- ↑ Fungal infections of farmed salmon and trout Archived 2012-10-24 at the Wayback Machine Retrieved 2012-02-06.
- 1 2 3 4 Rédou, Vanessa; Navarri, Marion; Meslet-Cladière, Laurence; Barbier, Georges; Burgaud, Gaëtan (2015-05-15). Brakhage, A. A. (ed.). "Species Richness and Adaptation of Marine Fungi from Deep-Subseafloor Sediments". Applied and Environmental Microbiology. 81 (10): 3571–3583. Bibcode:2015ApEnM..81.3571R. doi:10.1128/AEM.04064-14. ISSN 0099-2240. PMC 4407237. PMID 25769836.
- 1 2 Mouton, Marnel; Postma, Ferdinand; Wilsenach, Jac; Botha, Alfred (August 2012). "Diversity and Characterization of Culturable Fungi from Marine Sediment Collected from St. Helena Bay, South Africa". Microbial Ecology. 64 (2): 311–319. doi:10.1007/s00248-012-0035-9. ISSN 0095-3628. PMID 22430506. S2CID 9724720.
- ↑ Shoun, H.; Tanimoto, T. (1991-06-15). "Denitrification by the fungus Fusarium oxysporum and involvement of cytochrome P-450 in the respiratory nitrite reduction". The Journal of Biological Chemistry. 266 (17): 11078–11082. doi:10.1016/S0021-9258(18)99130-1. ISSN 0021-9258. PMID 2040619.
- ↑ Kilias, Estelle S.; Junges, Leandro; Šupraha, Luka; Leonard, Guy; Metfies, Katja; Richards, Thomas A. (2020). "Chytrid fungi distribution and co-occurrence with diatoms correlate with sea ice melt in the Arctic Ocean". Communications Biology. 3 (1): 183. doi:10.1038/s42003-020-0891-7. PMC 7174370. PMID 32317738. S2CID 216033140.
Modified text was copied from this source, which is available under a Creative Commons Attribution 4.0 International License. - ↑ Hassett, B. T.; Gradinger, R. (2016). "Chytrids dominate arctic marine fungal communities". Environmental Microbiology. 18 (6): 2001–2009. doi:10.1111/1462-2920.13216. ISSN 1462-2920. PMID 26754171.
- ↑ Kagami, M., Miki, T. and Takimoto, G. (2014) "Mycoloop: chytrids in aquatic food webs". Frontiers in microbiology, 5: 166. doi:10.3389/fmicb.2014.00166.
Modified text was copied from this source, which is available under a Creative Commons Attribution 3.0 International License. - ↑ Gutierrez MH, Jara AM, Pantoja S (2016) "Fungal parasites infect marine diatoms in the upwelling ecosystem of the Humboldt current system off central Chile". Environ Microbiol, 18(5): 1646–1653. doi:10.1111/1462-2920.13257.
- ↑ Frenken, T., Alacid, E., Berger, S.A., Bourne, E.C., Gerphagnon, M., Grossart, H.P., Gsell, A.S., Ibelings, B.W., Kagami, M., Küpper, F.C. and Letcher, P.M. (2017) "Integrating chytrid fungal parasites into plankton ecology: research gaps and needs". Environmental microbiology, 19(10): 3802–3822. doi:10.1111/1462-2920.13827.
Modified text was copied from this source, which is available under a Creative Commons Attribution 4.0 International License.
- ↑ Barranco, V.S., Van der Meer, M.T., Kagami, M., Van den Wyngaert, S., Van de Waal, D.B., Van Donk, E. and Gsell, A.S. (2020( "Trophic position, elemental ratios and nitrogen transfer in a planktonic host–parasite–consumer food chain including a fungal parasite". Oecologia: 1–14. doi:10.1007/s00442-020-04721-w.
Modified text was copied from this source, which is available under a Creative Commons Attribution 4.0 International License. - 1 2 Moghadamtousi, Soheil; Nikzad, Sonia; Kadir, Habsah; Abubakar, Sazaly; Zandi, Keivan (2015-07-22). "Potential Antiviral Agents from Marine Fungi: An Overview". Marine Drugs. 13 (7): 4520–4538. doi:10.3390/md13074520. ISSN 1660-3397. PMC 4515631. PMID 26204947.
- 1 2 Deshmukh, Sunil K.; Prakash, Ved; Ranjan, Nihar (2018-01-05). "Marine Fungi: A Source of Potential Anticancer Compounds". Frontiers in Microbiology. 8: 2536. doi:10.3389/fmicb.2017.02536. ISSN 1664-302X. PMC 5760561. PMID 29354097.
- ↑ Zhou, Songlin; Wang, Min; Feng, Qi; Lin, Yingying; Zhao, Huange (December 2016). "A study on biological activity of marine fungi from different habitats in coastal regions". SpringerPlus. 5 (1): 1966. doi:10.1186/s40064-016-3658-3. ISSN 2193-1801. PMC 5108748. PMID 27933244.
- ↑ Xu, Lijian; Meng, Wei; Cao, Cong; Wang, Jian; Shan, Wenjun; Wang, Qinggui (2015-06-02). "Antibacterial and Antifungal Compounds from Marine Fungi". Marine Drugs. 13 (6): 3479–3513. doi:10.3390/md13063479. ISSN 1660-3397. PMC 4483641. PMID 26042616.
Further reading
- Gareth Jones, E. B. and Pang, Ka-Lai (2012) Marine Fungi: and Fungal-like Organisms Marine and Freshwater Botany Walter de Gruyter. ISBN 9783110264067.
- Raghukumar, Chandralata (2012) Biology of Marine Fungi Springer. ISBN 9783642233425.
- Raghukumar, Seshagiri (2017) Fungi in Coastal and Oceanic Marine Ecosystems Springer. ISBN 9783319543048.
